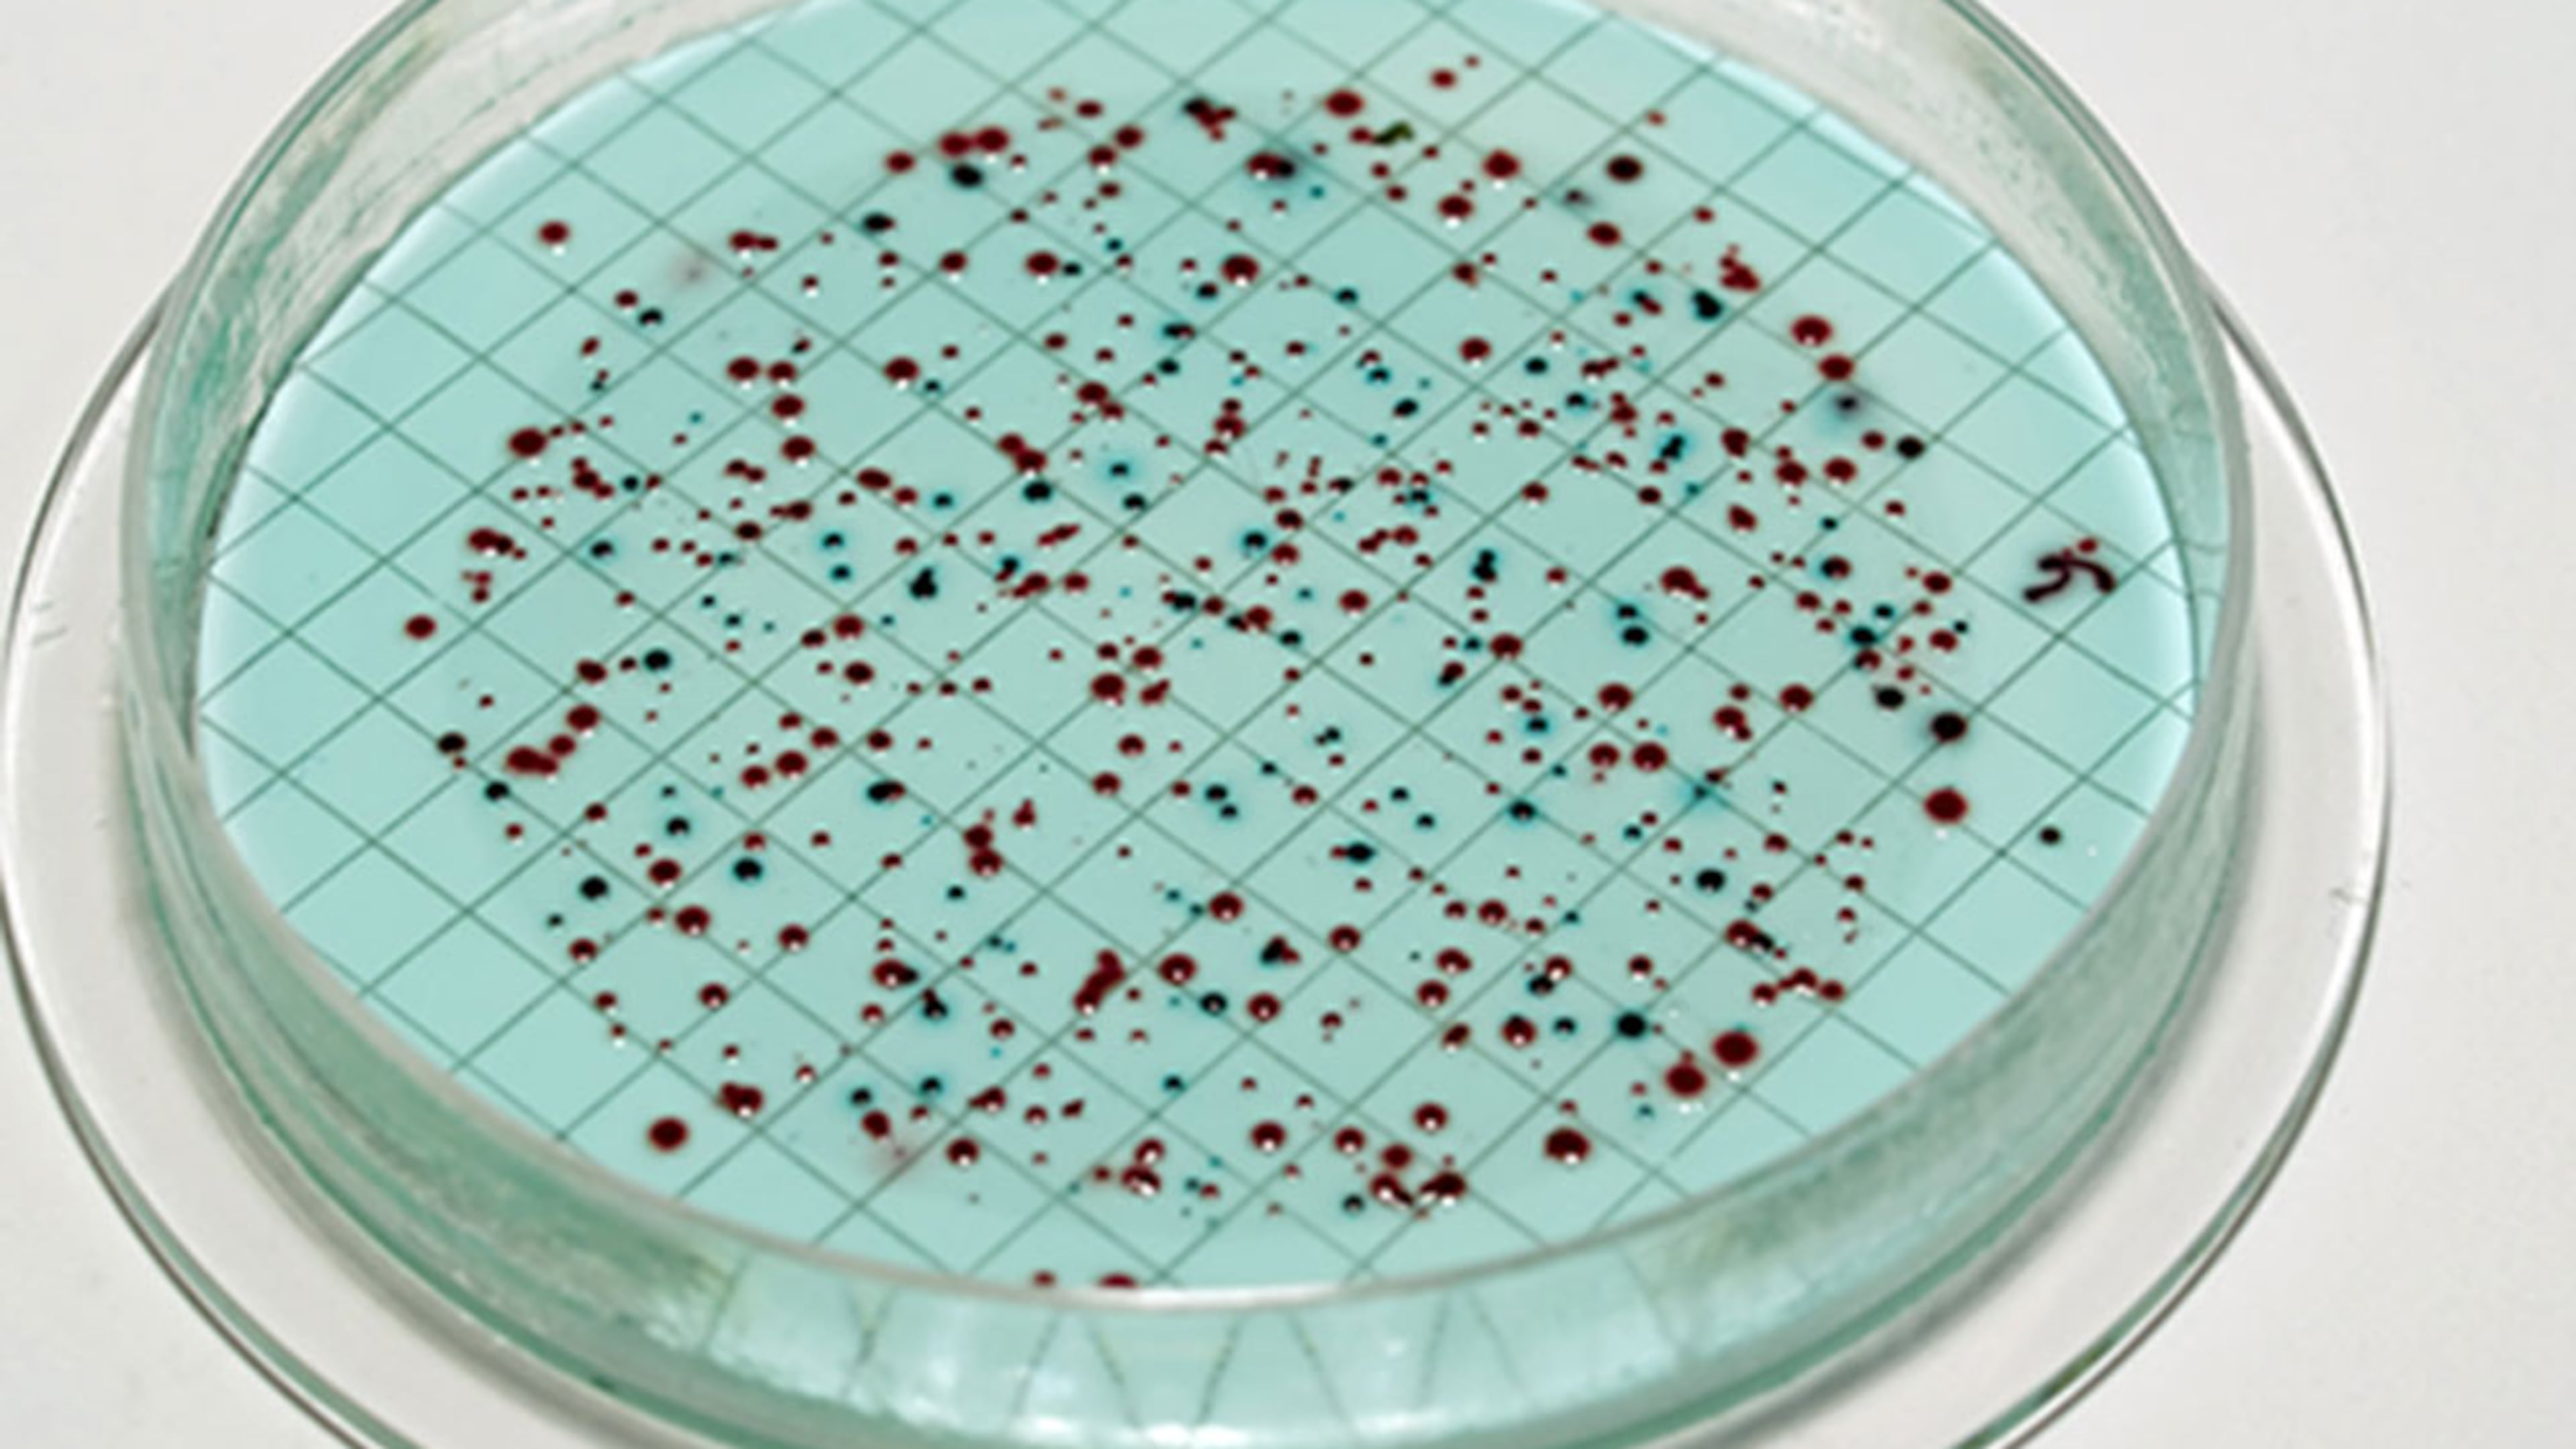
Bacteria come in many forms, but Vibrio vulnificus, a rare and potentially deadly bacteria found in warm salt water has prompted health officials to warn those who venture into Florida's waters to be wary, especially if you have any open cuts.

Year in review: Top 5 health stories of 2015
- Watch kids choose between a gift for themselves or their parents
- Mother of handicapped girl chastises driver who wrote nasty note
- Reports: 37 injured, 1 dead in accident on Las Vegas Strip
- Little girl mistakes Walmart shopper for Santa
- High school teen killed shielding 3 girls from gunfire
From controversial studies to health warnings and disease outbreaks, 2015 was another busy health news year. Here is a roundup of the most popular health news stories of 2015.
1.) Health officials warn of 'rare' flesh-eating bacteria in Florida
In June, Florida health officials warned beach goers about the appearance of the rare, potentially deadly Vibrio vulnificus bacterium. Over 30 cases of infection and several related deaths were reported over the past year in Florida. Vibrio can be contracted by consuming or handling raw shellfish or by swimming in warm saltwater areas.
2.) E-cigarette chemical linked to 'popcorn lung'
A study examining the flavoring chemicals of e-cigarettes found the chemical diacetyl in 75 percent of tested products. Diacetyl, a flavoring chemical used in microwave popcorn, has been linked to a lung disease nicknamed “popcorn lung.” The disease, officially known as bronchiolitis obliterans, causes scarring in the lungs.
Your mother may not agree, but health experts claim that not making your bed may be good for your health. That’s because leaving your bed unmade helps dry out bedding and allows dust mites to die easier than keeping them in a warm, moist environment of a made bed. Dust mites can cause or aggravate asthma and allergies.
4.) This bug could give you the 'kiss' of death
An outbreak in Texas of Chagas disease had people scrambling to find out more about the so-called “kissing bugs.” Once a tropical disease, at least a dozen people were infected in Texas. The kissing bugs tend to bite people’s faces and lips, and carry a parasite which causes Chagas disease, which in rare cases can be deadly.
5.) Police warn if you get these in your trick-or-treat bag, they're not candy
This warning from a Mississippi police department quickly went viral despite being widely debunked. The police warned parents to watch out for candy-shaped items in their kids’ trick-or-treat bags that could actually be ecstasy pills. Experts claim there has never been a reported case of such a thing happening.

